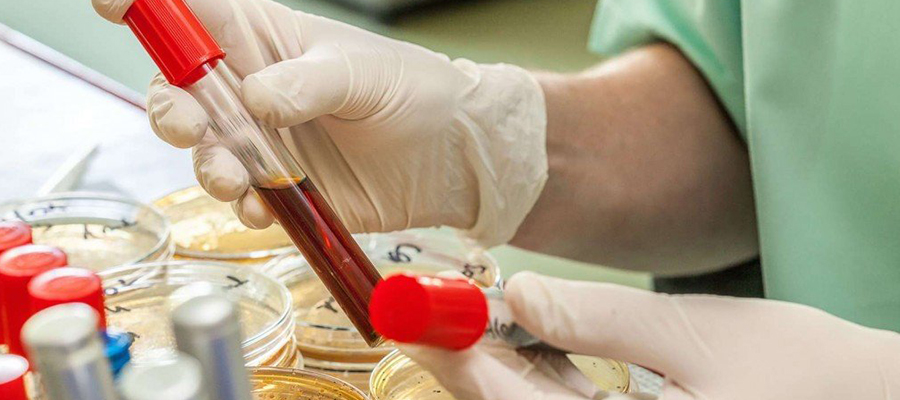
Anti HCV Testi

Anti HCV Hakkında Bilinmesi Gerekenler
Anti hcv testi, kişilerin karaciğerinde oluşan iltihaplanmalar genel olarak bu test sayesinde anlaşılır. Kişilerin karaciğerinde yaşamış oldukları rahatsızlıklar genel olarak karaciğerin iflas etmesine kadar götüren hastalık olarak bilinir. Kişilere anti HCV testi yaptırıldığı zamanlarda karaciğerde oluşan iltihaplanmalar meydana çıkar.
Hastalara test kolay bir şekilde yapılır. Hastaların kan örneği alınırken steril pamuk ile kol silinir. Steril pamuk ile silinen damar yolundan kan örneği alınır. Daha sonra alınan kan laboratuvar ortamlarda steril bir şekilde incelenir.
Anti HCV Nedir?
Zamanla anti HCV kişilerde karaciğer iflas etmesine yol açar. Zaman geçtikçe anti HCV genel olarak kişilerin karaciğer işlevinin yerine getirmemesi durumu da ortaya çıkar. Test yaptırmak kişilerde bulunan anti HCV virüsünün saptanması konusunda oldukça etkilidir.
Kişiler hastalıklarının farkına ne kadar erken varırlarsa o kadar iyidir. Çünkü kişiler hastalığını başkasına bulaştırmadan tedavi edilme imkanına sahip olur. Aynı zamanda kişilerin hastalıkları ilerlemeden önlenir.
Anti HCV Testi Nasıl Yapılır?
Kişiler belirli rahatsızlıklar yaşadıkları zamanlarda sağlık kuruluşlarına başvuru yaparlar. Sağlık kuruluşları istediği takdirde kişilerden anti hcv testi talep edebilirler.
Bu testin yapılması da oldukça basittir. Test yaptıracak kişilerin kolundan kan örneği alınır. Alınan kan örneği sağlık kuruluşları tarafınca steril ortamlarda incelenir. Bu testin yapılması için hastalar sağlık kuruluşların ilgili alanlarına başvurmaları gerekir.
Anti HCV Testi Neden Yapılır
Kişiler herhangi birisinin kişisel eşyalarını kullandıktan sonra eşya sahibinin hepatit c olduğunu öğrendikten sonra anti HCV testi yapılır. Bu test genel olarak kişilerin herhangi bir teması sonucunda istenir. Yapılacak olan testin sonucunun pozitif veya negatif çıkması kişinin hasta olup olmadığı hakkında bilgi verir.
Hepatit c virüsü taşıyan kişi ile cinsel ilişki teması kurumuşsa eğer bu testin yaptırılması gerekir. Bazı kişilerde genetik bir rahatsızlık olarak meydana çıkar.
Kişiler genetik rahatsızlık olduğunu bildikleri zamanlarda kişide hastalığın bulunup bulunmaması için test yaptırılması gerekir.
Test yaptırılmadığı zamanlarda kişilerde halsizlik belirtisi ile birlikte vücuda hastalık yayılır. Kişiler dikkat etmedikleri sürece ve kişilerde bulunan bu hastalık ilerlemiş olduğunda fark edilirse tehlikelidir.
Anti HCV Testi Aç Karnına Mı Yapılır?
Belirti yaşayan kişiler ve genel olarak şüphe duyan kişiler test yaptırmanın doğru olduğunu düşünürler. Bu yüzden test yaptıracak olan kişiler anti HCV testi aç karnına mı yapılır yoksa tok karnına mı test yapılır gibi soruları merak ederler. Test yaptırmak isteyen kişiler öncelikle doğru birimde ön muayeneden geçmesi gerekir.
Ön muayeneden geçen hastaya doktor gereken bilgileri verir. Kişilerin yapısına göre yapılacak olan test aç veya tok karnına yapılır. Burada kişinin sağlığı ve başka hastalıklarının bulunup bulunmaması önemli bir nokta olarak bilinir.
Anti HCV Testi Kaç Günde Çıkar
Kişiler herhangi bir şüphe veya belirti duydukları zamanlarda test yaptırmayı tercih ederler. Genel olarak test yaptıran kişiler daha sonra testin kaç gün içerisinde sonuçlanacağını da merak ederler. Sağlık kuruluşları tarafından yapılmış olan test sonucu belirli bir süre zarfında sonuçlanır.
Bazı sağlık kuruluşları kişilerden kan örneği ve idrar örneği isterler. Bu sağlık kuruluşları kısa bir süre içerisinde kan örneği sonucunu ve idrar örneği sonucunu çıkarmak isterler.
Kişilerin kan örneği ve idrar örneği vermeleri yeterli değildir. Genel olarak kişilerin gitmiş oldukları hekimler de muayene yapacakları için tahlil sonuçları erken çıkar.
Anti HCV Pozitif Ne Anlama Gelir?
Anti HCV virüsü genel olarak karaciğer odaklı oluşan bir hastalık olarak karşımıza çıkar. Bu hastalık genel olarak kişilerin karaciğerinde sürekli olarak meydana gelerek kişilere belirtiler verir. Kişilerin yaptırmış olduğu anti HCV testi pozitif çıktığı zaman kişinin hepatit c virüsü olduğu bilinir.
Bu virüs tedavi edilmediği zamanlarda ölümle sonuçlanır. Kişiler tedavilerine dikkat etmedikleri zamanlarda siroz hastalığına yakalanırlar.
Siroz hastalığının yanı sıra kişiler ileriki zamanlarda kanser hastalığı ile de karşı karşıya kalırlar. Hepatit c virüsü genel olarak çoğu durumlarda kişinin vücudunda kendini belli etmez. Bu nedenle kişilerin sıklıkla test yaptırmaları önerilir.
Anti HCV Negatif Ne Anlama Gelir?
Kişiler anti HCV testi yaptırdıkları zaman negatif sonucu ile karşılaşabilirler. Yapılan testte negatif sonucu kişilerin hepatit c virüsü taşımadığı anlamına gelir.
Testler genel olarak sağlık kuruluşları tarafından steril ortamlarda yapılır. Kişiler her an dikkat etmeleri gerekir. Her bireyin kanı ile temasa geçmemeye özen göstermesi gerekir.
Bunun nedeni aslında hepatit c taşıyan bir kişinin kanı ile temasa geçildiği zaman bu virüsün bulaşma oranının fazla olduğu bilinir.
Kişiler herhangi birinin kişisel eşyasını ve medikal cihazlarını kullanmamaları gerekir. Bunun nedeni de virüsün bazı yollar ile rahat bulaşabilecek olmasıdır. Kişilerin şüphe yaşadıkları zamanlarda mutlaka test yaptırması gerekir.
Anti HCV Testi Fiyatları 2026
Kişiler bazı durumlar sonucunda test yaptırmak isterler. Bu bireylerin en temel hakkı olarak da bilinir. Bu nedenle kişiler test fiyatlarının sağlık kurumlarında ne kadar olduğu hakkında bilgi sahibi olmak isterler. Genel olarak şüphe duyan kişiler test yaptırma konusunda oldukça kararlı olurlar.
Bu nedenle sağlık kuruluşlarını araştırmaya başlarlar. Çünkü yapılacak olan testin fiyatları her hastaneye göre farklılık gösterir. Bu nedenle kişiler Anti HCV testi yaptırmadan önce geniş çaplı araştırma yapmaları gerekir. Anti hcv testi fiyatları 2026 hakkında bilgi almak için bizlere hemen ulaşabilirsiniz.


